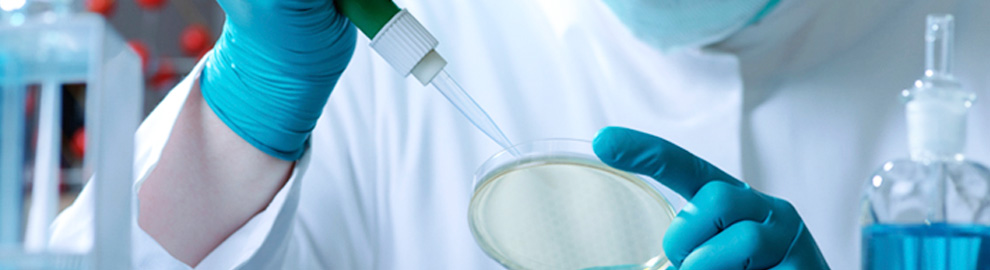

+91 98452 75111
TECHNALOGY TRANSFER
Whether you are expanding current capability by adding other dosage forms or developing a breakthrough application, Foray Life Care has the required analytical experience and technical know-how to help product and process development.
Foray Life Care supports clients in pharmaceutical development to ensure innovative quality pharma products in a cost effective way throughout their life cycle.
This involves:
Identification of most suited delivery systems.
Development of the manufacturing process to ensure consistent manufacturing on a viable, commercial scale.
A dynamic maintenance to improve or change the manufacturing process, if required
Foray Life Care News
© Copyright 2012, Foray Life Care. All Rights Reserved.